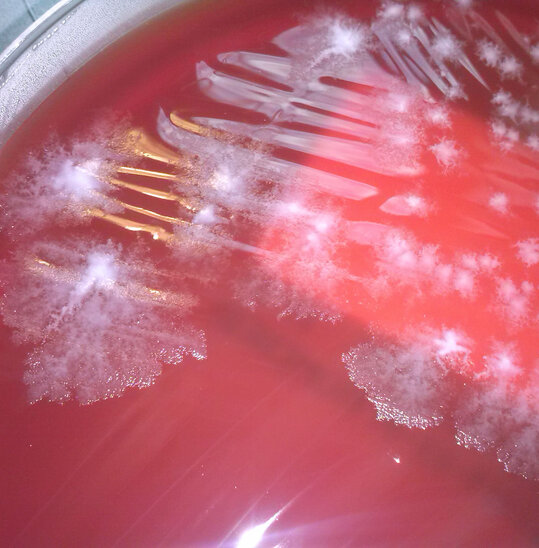

Krankenhaushygiene am UKS
Wie das UKS für einen optimalen Schutz vor Infektionen sorgt
Die Krankenhaushygiene ist der Schutzschild gegen Infektionen im Krankenhaus. Gezielte Maßnahmen und strenge Hygienestandards sorgen für die Gesundheit der Patientinnen und Patienten.
Warum die Krankenhaushygiene so wichtig ist
Unser Ziel am Universitätsklinikum des Saarlandes (UKS) ist es, den Patientinnen und Patienten eine optimale Pflege und Behandlung im Krankenhaus zu bieten, damit der Therapieerfolg sichergestellt ist. Manchmal kann jedoch die Grunderkrankung, die zur Aufnahme geführt hat, das Immunsystem schwächen. Auch bestimmte therapeutische Maßnahmen können das Risiko für Krankenhausinfektionen, sogenannte nosokomiale Infektionen, erhöhen. Gemeinsam wollen wir solche Infektionen verhindern und Infektionsprävention betreiben.
Dieses Ziel erreichen wir nur durch eine enge Zusammenarbeit zwischen dem medizinischen Team und den Patientinnen und Patienten. Die Abteilung für Krankenhaushygiene am UKS koordiniert und verbessert die Strukturen und Voraussetzungen für eine optimale Infektionsprävention und Hygiene.
Dazu gehören
- die Entwicklung von Hygiene-Plänen nach dem neuesten Stand der Wissenschaft,
- die Begleitung hygienischer Abläufe in den Kliniken,
- das Management von Infektionsausbrüchen
- und das Pandemie-Management.
Unser Ziel ist es, die Infektionsprävention am UKS wirkungsvoll und effektiv zu gestalten und für optimale Hygiene zu sorgen.
Notfälle außerhalb der Dienstzeiten
Bei Notfällen außerhalb der Dienstzeiten kann unser Bereitschaftsdienst über
+49 6841 16-23912
oder über die Pforte der Inneren Medizin
+49 6841 16-15000
alarmiert werden.
Kontakt & Anschrift
Universitätsklinikum des Saarlandes
Institut für Medizinische Mikrobiologie und Hygiene
Abteilung Krankenhaushygiene
Gebäude 43, 66421 Homburg
Sekretariat der Krankenhaushygiene
& Allgemeine Anfragen
+49 6841 16-23966
krankenhaushygiene☞ Bitte fügen Sie an dieser Stelle ein @ ein ☜uks☞ Bitte fügen Sie an dieser Stelle einen Punkt ein ☜eu
Gesundheitsmanager
Dr. Uwe Schlotthauer, M.Sc. Public Health
+49 6841 16-23917
+49 6841 16-23994
uwe.schlotthauer☞ Bitte fügen Sie an dieser Stelle ein @ ein ☜uks☞ Bitte fügen Sie an dieser Stelle einen Punkt ein ☜eu
Sekretariat
Eveline Päßler
Sekretariat Krankenhaushygiene
+49 6841 16-23966
+49 6841 16-23985
eveline.paessler☞ Bitte fügen Sie an dieser Stelle ein @ ein ☜uks☞ Bitte fügen Sie an dieser Stelle einen Punkt ein ☜eu
Ihr Weg zu uns
Anfahrt, Parken, Klinikbus und Klinikumspläne
Anfahrt zum Klinikum
Mit dem eigenen PKW
Aus Richtung Mannheim bzw. Saarbrücken kommend
Autobahn A6 Ausfahrt Homburg, Richtung Homburg abbiegen, der Beschilderung Kliniken/Universitätskliniken folgen.
Aus Richtung Trier bzw. Koblenz kommend
Autobahn A8 bis Autobahnkreuz Neunkirchen, dort wechseln auf die Autobahn A6 in Richtung Mannheim bis zur nächsten Ausfahrt Homburg, dann der Beschilderung Kliniken/Universitätskliniken folgen.
Aus Richtung Karlsruhe/Pirmasens kommend
Bundesstraße 10, anschließend ab Pirmasens Autobahn A 8 bis zur Ausfahrt Einöd, über die Bundesstraße 423 nach Homburg und dann der Beschilderung Kliniken/Universitätskliniken folgen.
Hinweis für die Routenplanung mit Navigationsgeräten
Das Klinikum hat die eigene Postleitzahl 66421. Sollte Ihr Navigationsgerät diese eigene PLZ nicht erkennen, können Sie als Adressangabe alternativ "Kirrberger Straße 100, 66424 Homburg" verwenden. Diese Hausnummer wird real nicht verwendet, entspricht aber der Hauptzufahrt zum Klinikum!
Anfahrt zum Klinikum
Mit öffentlichen Verkehrsmitteln (ÖPNV)
Anreise mit der Bahn
InterCityExpress ab Frankfurt, Mannheim, Saarbrücken oder Paris sowie Regionalbahn Kaiserslautern – Trier und Regionalexpress Mannheim – Koblenz) bis Homburg Hauptbahnhof.
Das Klinikum erreichen Sie vom Hauptbahnhof aus
mit dem Taxi (Fahrzeit ca. 10 Minuten) oder den Stadtbuslinien 511 und 512 (Bussteig G) und der Buslinie 505 (Bexbach – Höchen – Uniklinik, Bussteig C). Das Universitätsklinikum ist werktags tagsüber fünf Mal stündlich an den Homburger Hauptbahnhof und das Stadtzentrum angeschlossen. Das Universitätsklinikum ist auch mit der Linie 315 (Uniklinikum – Beeden – Limbach – Zentralfriedhof/Furpach – Neunkirchen) zu erreichen. Alle Linien verkehren auch regelmäßig an Wochenenden und Feiertagen.
Infos zum Fahrplan unter www.saarfahrplan.de. Fahrpläne auch im Stadtbusbüro Homburg oder im Infozentrum des Klinikums (Gebäude 10, direkt am Haupteingang).
Anfahrt zum Klinikum
Parken auf dem Campus
Das Klinikum verfügt über eine Reihe von kostenpflichtigen Parkplätzen auf dem Campus - wir empfehlen aber das Parkhaus an der Hauptzufahrt zum Klinikum. Hier finden Sie ausreichend Parkmöglichkeiten und von hier startet auch unser kostenloser Klinikumsbus im 15 Minuten-Takt, mit dem Sie alle Kliniken auf dem Campus bequem erreichen können.
Für Patienten, die stationär aufgenommen oder abgeholt werden, stehen auf dem Campus in unmittelbarer Nähe der Kliniken gebührenpflichtige Kurzzeitparkplätze zur Verfügung. Es handelt sich dabei um je einen Parkbereich mit mehreren Stellplätzen im Bereich der Inneren Medizin (IMED, G41), Augenklinik (G24), Frauen-/Kinderklinik (G9), Nervenklinik (G90), Neurochirurgie (G90), Nuklearmedizin (G50) und Rechtsmedizin (G49.1). Diese Parkplätze sind in der Zeit von 7:00 Uhr bis 18:00 gebührenpflichtig (Höchstparkdauer – 1 Tag; Parkgebühren - je 30 Min. 0,50 €; Mindestgebühren – 0,50 €; Höchstgebühren – 6,00 €)


Kostenloser Klinikbus am UKS
Innerhalb des Klinikums können Sie den kostenlosen Klinikbus benutzen. Der Bus fährt von 7:00 bis 16:00 Uhr im 15-Minuten-Takt. Der Bus fährt in 15 Minten einen Rundkurs durch das gesamte Gelände und hält dabei an 12 Haltestellen (siehe Lageplan).
Infozentrum – Ihr Ansprechpartner bei Fragen rund ums Klinikum
Im Info-Zentrum erhalten Sie Auskunft und Informationsmaterial rund ums Klinikum – die Mitarbeiter des Info-Zentrums stehen Ihnen für Fragen zur Verfügung und halten Übersichtspläne vom Gelände und Abfahrtzeiten der im Gelände verkehrenden Busse bereit. Hier befindet sich auch das Fundbüro des UKS, werden Mitarbeiterausweise erstellt und ausgegeben. Das Infozentrum hält auch Infomaterial zu kulturellen Veranstaltungen der Stadt Homburg, der Stadt Zweibrücken und der Region bereit. Das Info-Zentrum (Gebäude 10) befindet sich direkt an der Hauptpforte des UKS und dient als erste Anlaufstelle für alle Ratsuchenden, die das Gelände des Universitätsklinikums betreten.
Öffnungszeiten des Infozentrums
Montags bis freitags von 7:30 bis 16:15 Uhr
+49 6841 16 - 0
info☞ Bitte fügen Sie an dieser Stelle ein @ ein ☜uks☞ Bitte fügen Sie an dieser Stelle einen Punkt ein ☜eu

Zugriff auf interne Info- und Arbeitsdokumente
Im UKS-Intranet (Confluence) erhalten alle UKS-Mitarbeiterinnen & Mitarbeiter Zugriff auf eine Vielzahl von internen Dokumenten, Ressourcen und Informationen, die für ihre tägliche Arbeit und Zusammenarbeit unerlässlich sind. Die Nutzung des Intranet-Portals ist nur innerhalb des UKS-Kliniknetzwerks und nur mit Anmeldung über die AD-Kennung möglich. Greifen Sie auf interne Richtlinien, Handbücher, Präsentationen und mehr zu – alles an einem zentralen Ort.